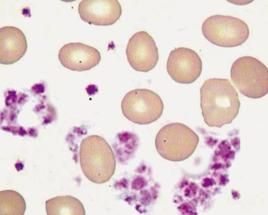
平均血小板體積 平均血小板體積

血小板體積
紅細胞與血小板MPV減少可見於脾亢,化療後,再障,巨幼細胞性貧血等。骨髓造血功能衰竭時,MPV與PLT(血小板)同時持續下降;造血功能抑制越嚴重,MPV越小。
血小板的範圍正常值是在100000—300000左右,但是很多情況可以因起的有生理性的正常人一般一天有6%-10%的變化,早上較低,午後較略高,春天較低冬天略高,高原地區較高,月經後增高,運動後增高。病理性的骨髓增生性疾病,原發性血小板增多症,急性溶血,急性化膿性感染。若出現血小板偏高的情況,應先注意觀察,過陣子再依次檢查,如果還是高那就要找出怎么引起的。
人在某種炎性因素作用下的炎性反應可導致血小板的升高,而其他值均正常。正常的血小板含量為100-300*10^9/L。略高於正常值的人,如果其他值正常及沒有症狀,一般不會有問題。只是血小板參與凝血,於是值較高會增加血栓形成的可能。
血小板增多:當>400x109/L時為血小板增多,原發性血小板增多常見於骨髓增生性疾病,如慢性粒細胞白血病,真性紅細胞增多症,原發性血小板增多症等;反應性血小板增多症常見於急慢性炎症,缺鐵性貧血及癌症患者,此類增多一般不超過500×109/L,經治療後情況改善,血小板數目會很快下降至正常水平。
檢查參數
平均血小板體積MPV正常參考值:9--13fl。
| 血小板正常MPV正常 | 正常人,骨髓增殖狀態,原發性高血壓,代償性血小板減少症 |
| PLT降低MPV正常 | 狼瘡,骨髓一直恢復期,特異性血小板減少性紫癜 |
| PLT降低MPV升高 | 子癇前兆,急性心肌炎,心源性肥大性骨關節病,免疫性血小 板減少紫癜,糖尿病 |
| PLT升高MPV正常 | 骨髓增生性疾病,反應性血小板增生與大面積的炎症,感染, 及營養性疾病 |
| PLT降低MPV降低 | AIDS,發育不良性貧血,脾亢,骨髓纖維化或腫瘤細胞浸潤危 及造血時,單純巨核細胞發育不全,再生障礙性貧血,骨髓化療 後,敗血症,巨幼貧血,遺傳性Wiskott-Aldrich綜合症 |
| PLT升高MPV升高 | 慢粒,脾切除術後,反應性血小板增多症和缺鐵的病人 |
| PLT正常MPV升高 | 慢性骨髓白血病,骨髓纖維化,脾切除,半數的α型和β型地 中海貧血 |
| PLT升高MPV降低 | 再生障礙性貧血,巨幼貧血和藥物引起的骨髓抑制 |
臨床意義
平均血小板體積(MPV)的臨床意義:
1)鑑別血小板減少的原因:骨髓造血功能損傷致使血小板減少時,MPV減少;血小板在周圍血液中破壞增多而減少時,MPV增大;血小板分布異常致血小板減少時,MPV正常。
2)MPV增大可作為骨髓造血功能恢復的較早期指症:骨髓造血功能衰竭時。MPV與PLT同時持續下降;造血功能抑制越嚴重,MPV越小;當造血功能恢復時,MPV增大常先於PLT升高。
3)MPV增大可見於:骨髓纖維化、原發性血小板減少性紫癜、血栓性疾病及血栓前狀態。脾切除、慢粒、巨大血小板綜合症、鐮刀細胞性貧血等。
4)MPV減少可見於:脾亢、化療後、再障、巨幼細胞性貧血等。
臨床血液學檢測
| 血液一般檢測包括血液細胞成分的常規檢查、網織紅細胞檢測和紅細胞沉降率檢測。近年來由於血液學分析儀的廣泛套用,血液常規檢測的項目日益增多。本任務是關於臨床血液學檢測的相關詞條。 |